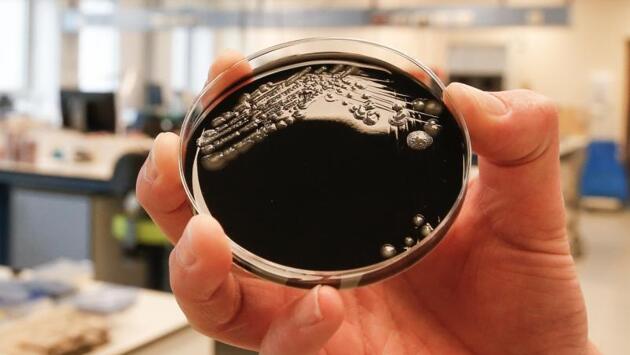

Кишечные бактерии могут сделать лекарства бесполезными
Исследование показало, каким именно образом кишечные бактерии могут влиять на эффективность работы лекарств.
До последнего времени ученые не понимали, почему некоторые лекарства отлично работают в организме одних людей и не вызывают никакого отклика в организме других. Десятилетиями проводились сравнения, которые не приводили ни к каким однозначным выводам. И вот теперь ученые из Йельского университета в США предположили, что виной подобных различий является уникальный микробиом бактерий кишечника.
Отметим, что лишь недавно наука начала изучать воздействие кишечной микрофлоры на эффективность терапевтических препаратов. Мы знаем, что некоторые лекарства взаимодействуют со специфическими микробами в кишечнике, которые либо усиливают их активность, либо делают их бесполезными или токсичными. Новое исследование позволило систематизировать данные специфические взаимодействия, поскольку его авторы следили за воздействием 76 штаммов кишечных бактерий на почти три сотни препаратов.
В ходе первого исследования подобного рода ученые измерили, как количество разных бактерий влияет на эффективность более 270 лекарств. Выяснилось, что 176 лекарств подвергаются негативному воздействию по крайней мере одного кишечного штамма. Следовательно, кишечные бактерии действительно могут оказывать самое широкое влияние на лекарства и именно это является причиной того, почему для некоторых пациентов они оказываются неэффективными.